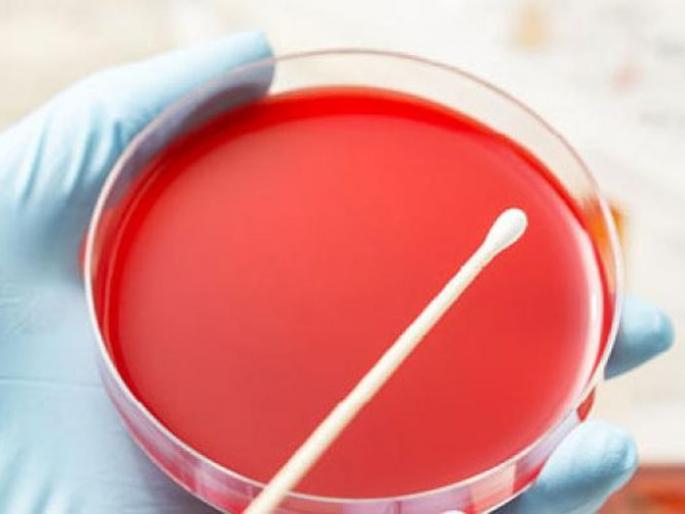
CoronaVirus: Waiting for the 'throat swab' report of 'those' five people | CoronaVirus : ‘त्या’ पाच जणांच्या ‘थ्रोट स्वॅब’ अहवालाची प्रतिक्षा CoronaVirus: Waiting for the 'throat swab' report of 'those' five people | CoronaVirus : ‘त्या’ पाच जणांच्या ‘थ्रोट स्वॅब’ अहवालाची प्रतिक्षा

CoronaVirus : ‘त्या’ पाच जणांच्या ‘थ्रोट स्वॅब’ अहवालाची प्रतिक्षा
By लोकमत न्यूज नेटवर्क | Updated: April 28, 2020 16:21 IST2020-04-28T16:21:49+5:302020-04-28T16:21:54+5:30
पाचही जणांचे ‘थ्रोट स्वॅब’ तपासणीसाठी प्रयोगशाळेत पाठविण्यात आले आहेत.
CoronaVirus : ‘त्या’ पाच जणांच्या ‘थ्रोट स्वॅब’ अहवालाची प्रतिक्षा
लोकमत न्यूज नेटवर्क
वाशिम : अमरावती येथील रहिवासी तथा वाशिम जिल्ह्यातील कामरगाव (ता.कारंजा) येथील एका शाळेवर कार्यरत शिक्षक कोरोनाबाधित असल्याचे २५ एप्रिल रोजी निष्पन्न झाले. या शिक्षकाच्या थेट संपर्कात आल्यामुळे कामरगाव येथील पाच जणांना जिल्हा सामान्य रुग्णालयातील विलगीकरण कक्षात दाखल केले असून, या पाचही जणांचे ‘थ्रोट स्वॅब’ तपासणीसाठी प्रयोगशाळेत पाठविण्यात आले आहेत. आता त्याचा अहवाल नेमका काय येतो, याकडे जिल्ह्याचे लक्ष लागले आहे.
कामरगावमधील प्रकारामुळे सजग झालेल्या प्रशासनाने २६ एप्रिल रोजी प्रशासनाने तातडीची पावले उचलत गावातील २०० जणांची प्राथमिक आरोग्य तपासणी केली. त्यांच्यात कोरोनाची कुठलीही लक्षणे आढळली नाहीत; मात्र थेट संपर्कात आलेले तीन शिक्षक व दोन नागरिक अशा पाच जणांना २६ एप्रिल रोजी विलगीकरण कक्षात दाखल करण्यात आले.आणि त्यांचे ‘थ्रोट स्वॅब’ नमुने २७ एप्रिल रोजी प्रयोगशाळेकडे पाठविण्यात आले. अमरावती जिल्ह्यात वाढत असलेला कोरोना विषाणूचा संसर्ग आणि त्याच्या संपर्कात आलेल्या पाच जणांमुळे कामरगाव परिसरात भीतीचे वातावरण निर्माण झाले असून, या पाचही जणांच्या ‘थ्रोट स्वॅब’ अहवालाची प्रतिक्षा जिल्हावासियांना आहे.